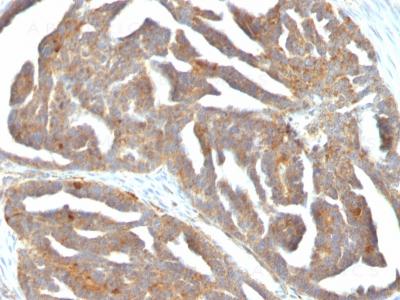

Monoclonal Antibody to GnRH-Receptor / LH-RH Receptor(Clone : F1G4; same as GNRH03)
Formalin-fixed, paraffin-embedded human Ovarian Carcinoma stained with GnRH-Receptor Monoclonal Antibody (F1G4)
Roll over image to zoom in
Shipping Info:
For estimated delivery dates, please contact us at [email protected]
Format : | Purified |
Amount : | 100 µg |
Isotype : | Mouse IgG1, kappa |
Purification : | Affinity Chromatography |
Content : | 100 µg in 500 µl PBS containing 0.05% BSA and 0.05% sodium azide. Sodium azide is highly toxic. |
Storage condition : | Store the antibody at 4°C; stable for 6 months. For long-term storage; store at -20°C. Avoid repeated freeze and thaw cycles. |
Flow Cytometry (1-2ug/million cells); Immunofluorescence (1-2ug/ml); Western Blot (1-2ug/ml); Immunohistochemistry (Formalin-fixed) (1-2ug/ml for 30 minutes at RT)(Staining of formalin-fixed tissues requires heating tissue sections in 1mM EDTA, pH 8.0, for 45 min at 95°C followed by cooling at RT for 20 minutes)
For Research Use Only. Not for use in diagnostic/therapeutics procedures.
H Li, XX Zhu, JB Xiang, L Jian Buserelin Inhibits the Immunosuppressive Activity of Regulatory T Cells through the Protein Kinase A Signaling in a Central Precocious Puberty Model. Immunological Investigations, 2021. https://doi.org/10.1080/08820139.2021.1885437
Wang X, Zhong L, Liu Q, Cai P, Zhang P, Lu Z, Li X, Liu J.
Activation of Gonadotropin-releasing Hormone Receptor Impedes the Immunosuppressive Activity of Decidual Regulatory T Cells via Deactivating the Mechanistic Target of Rapamycin Signaling.
Immunol Invest. 2022 Jul;51(5):1330-1346. doi: 10.1080/08820139.2021.1937208. Epub 2021 Jun 16.
PMID: 34132158.
There are currently no product reviews
|